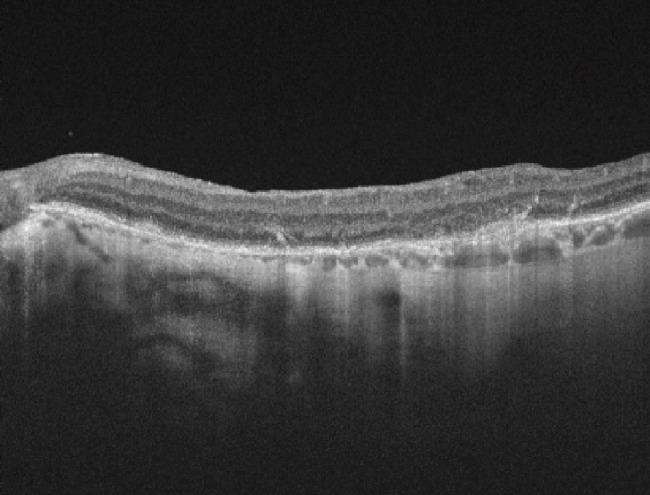

视网膜色素上皮萎缩继发内界膜和视网膜内界膜剥除术后:病例报告。
Retinal pigment epithelium atrophy after epiretinal membrane and internal limiting membrane peeling: case reports.
机构信息
Grupo Oftalmológico Abdala-Figuerola AF, Barranquilla, Colombia.
出版信息
Rom J Ophthalmol. 2022 Jan-Mar;66(1):79-83. doi: 10.22336/rjo.2022.16.
To describe the development of retinal pigment epithelium (RPE) atrophy after uncomplicated pars plana vitrectomy (PPV) with epiretinal membrane (ERM) and/or internal limiting membrane (ILM) peeling in 2 patients. : Case 1: A 79-years-old female with diagnosis of a full-thickness macular hole in her right eye (OD) with best corrected visual acuity (BCVA) of: 20/100 and left eye (OS): 20/70. After surgery she developed large RPE hyperplasia and presented hand movement that did not improve with pinhole. Case 2: A 69-years-old female patient who had ERM in her OS with BCVA of 20/30 in both eyes (OU). PPV was assisted with brilliant blue (BB) to better visualize the ILM. During follow-up visits we evidenced RPE atrophy in the zone where peeling was done. In the last control after 2-years, her visual acuity was 20/40 that did not improve with pinhole. There are three possible mechanisms to explain this complication: toxic damage, mechanical trauma during the membrane removal with forceps, or a combination of both. In our cases, a combination of them is probably the cause of the presence of RPE atrophy. Vitrectomy with membrane removal is successful in most cases with low rate of complications. Because RPE atrophy is infrequent, our suggestion is to continue performing this technique and if possible, it should be done without dye staining to minimize risks. ERM = epiretinal membrane, ILM = internal limiting membrane, MH = macular hole, RPE = Retinal pigment epithelium, OD = right eye, BCVA = Best corrected visual acuity, OS = left eye, OU = both eyes, IOL = intraocular lens, OCT = Optical coherence tomography, BB = Brilliant blue, TB = Trypan blue, ICG = indocyanine green.
描述 2 例单纯性孔源性视网膜脱离(PPV)伴内界膜(ILM)剥除术后无并发症的视网膜色素上皮(RPE)萎缩的发展。病例 1:一名 79 岁女性右眼(OD)全层黄斑裂孔,最佳矫正视力(BCVA):20/100,左眼(OS):20/70。手术后,她发生了较大的 RPE 增生,并出现手动视力,无法通过小孔改善。病例 2:一名 69 岁女性,OS 有 ERM,双眼 BCVA 为 20/30(OU)。PPV 采用亮蓝(BB)辅助,以更好地观察 ILM。随访时,我们在进行剥除的区域发现了 RPE 萎缩。最后一次随访 2 年后,她的视力为 20/40,无法通过小孔改善。有三种可能的机制可以解释这种并发症:毒性损伤、用镊子去除膜时的机械创伤,或两者的结合。在我们的病例中,两者的结合可能是 RPE 萎缩的原因。大多数情况下,膜切除玻璃体切除术是成功的,并发症发生率低。由于 RPE 萎缩并不常见,我们的建议是继续进行这种技术,如果可能的话,应在不染色的情况下进行,以降低风险。ERM = 视网膜内界膜,ILM = 内界膜,MH = 黄斑裂孔,RPE = 视网膜色素上皮,OD = 右眼,BCVA = 最佳矫正视力,OS = 左眼,OU = 双眼,IOL = 人工晶状体,OCT = 光学相干断层扫描,BB = 亮蓝,TB = 锥虫蓝,ICG = 吲哚青绿。